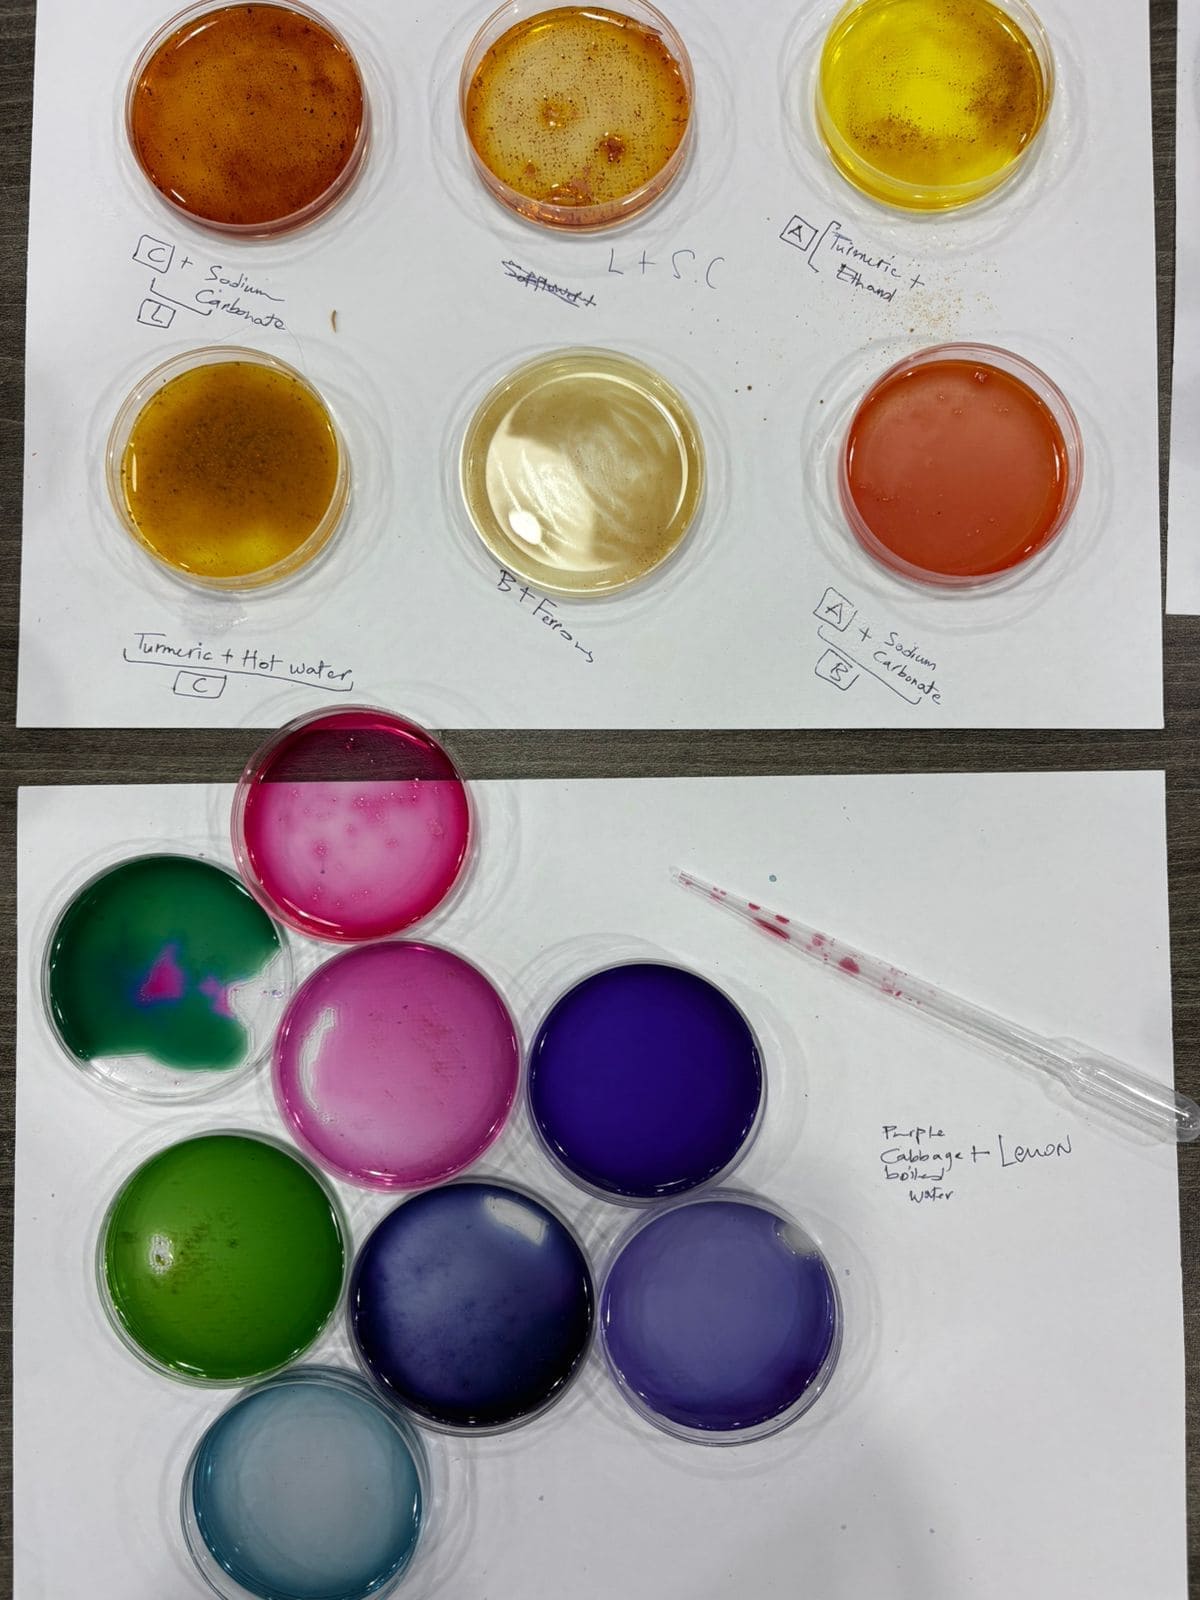

4. BioChromes¶
The more our world functions like the natural world, the more likely we are to endure on this home that is ours, but not ours alone. by Janine Benyus
Week Intro¶
This week has started totally diffrent . off the lab and involve in nature . learning from nature and gather ingrediant to experience it when return back to the lab.
The main objective of this week is to extract colors from nature
and use them on fabrics with understanding the natural fabic origins
if taken from animals or plants as the output shown on image above.
will talk more about it on the next sections.stay tuned!!
Research & Explore Journey¶
In this section i will take you with the story begin and our lab nature trip to learn from the mother nature and understand more about the plants with the instructor guide . then i will show you some of research and inspiration i found about the topic .
Trip to mother nature¶
Before trip there were two helpful apps to understand more about surrounded plants will surround you and know more about it ! to be identified as plants/leaves/fruits
Remamber to go with open heart to nature and good search method such as app, phone or even books . here are the apps i relied on with searcch engines help.
WHY Did I Collect nature things and elements ? And What is bio-chrome?
Story begin¶
For millions of years since humans lived in caves we have always felt the need to tell a story and leave a trace that proves we were here. Today that trace can be a photograph, a painting, or a film, but in the past the only way was to paint on cave walls, stones, and natural surfaces. That is why the image below shows examples of marks and drawings discovered from early human civilizations
But if you think with me how they paint ? what kind of colors?and even how it is still there after all these years?
Well from what we know they used animal blood, plants and draw on only natural resources!
See also below during Pharaons egyption period.

Today and Biochrome¶
The ecological benefits of natural dyeing today is the vision of paving the future with sustainable resources from nature by using and reserving our local resources . And guess what ? we can help our bodies and kids and next generations by minimizing the toxic chemical we are surrounded with! Don't you think it is worth it?
References & Inspiration¶
Shibori-Japan
Shibori’s roots in ancient Japan, where artisans used folding, binding, and stitching with natural fabrics like typically done on natural fabrics such as cotton, silk, or linen, primarily dyed with indigo. This technique symbolized harmony with nature and cultural identity. Traditional methods like Kanoko and Arashi created distinct patterns. Over time, Shibori spread worldwide, evolving through modern materials and sustainable practices. *photo credit :Woman Making Shibori by Utagawa Kunisada, 1845"*
Shibori Video¶
Biochrome Fundementals¶
See photo below the method used if you want to create your own natural colors as ink or liquid , depends if you use water for liquid or solvent for ink.
Natural dyes bond best with natural fibers, so I used natural fabrics (such as cotton, linen, silk, or wool), as shown below.
It is important to separate fabrics based on their source (plant-based vs animal-based) and avoid mixing them later in the same dye bath.
WORKFLOW¶
Check the photo below to see step by step the workflow to dye natural fabrics.
Weight of Fibre (WoF)¶¶
Scale Plants fibers and animal seperately .
as the first step is scale the weight of fibers and keep it as a note,as this will be effected by amount of alum and washing soda to be added on.

Scouring : Plant Fibres¶
Plant Fibres used here are : Cotton and linnen.
Add Soda to hot water
Soda amount= a 1 tsp to 1L ratio
leave it on *high heat* for 30 min .(and i=they can boil)
Then rinse it with a gradually temperature lowered water this first step of cleaning as SCOURING
Scouring : Animal Fibres¶
Animal Fibres used here : Wool and silk.
leave it on medium-to-low heat for 30 min.
Then rinse it with a gradually temperature lowered water until it becomes lukewarm and add a dash of hand soap for cleaning and massage it.
add dishsoap for the process of cleaning
Mordanting¶
After scouring it is time to rinse fibers and added it to boiling wter with 10% Alum of it is weight that scaled before scouring on (WOF) step and leave it on boiling water around an hour, then rinse them again with water.
Colors¶
Extract colors from waste of vegetables and fruits and here the first photo the color is a bit yellow-reddish extracted from onions outer surface. and the next photo the blue/violet color is extracted from Cabbage. you can defiantly try more and other fruit and vegetable surface and see the color could be extracted from by creating a dye path : 1- boil water . 2-then add slowly the fruits waste and stir the mix around 15 mins ,less or more time depends on the observation for the extracted color.
Extracted Colors¶
The step above shows the dye bath used to extract color. After the dye bath, the liquid is filtered into jars using any suitable filter; in this case, a coffee filter was used to keep only the colored water.
The filtered dye was then stored in the refrigerator for better preservation.
DYE Bath¶
Use filtered extracted colors in jars and put the fabric inside the jars then surround the jars with heated water and DO NOT Boil as shown in the picture below as this way dye the fabric . leave it between 30 mins - 2h.

Expirment ink colors¶
Modifiers¶
The photo below shows the cabbage color + lemonas a natural modifier and other mofifiers .each percentatge of modifier can give diffrent tunes brighter and even darder depend on the modifier characteristics. However i need to mention that copper sulphate the blue one the new studies shows its toxicity and have not used in my expirmentation and i hope you stay safe away from.
Fabric¶
Using the same technique of Shibori-Japan and following the workflow above this fabric was dyed !
The Sand here is from wadi-rum in Jordan and i deled with it by letting the sand resolve in the boiled water but defiantly i would still try it in future because wadi-rum dessert sand is unique blend of red and ochre, created by the erosion of sandstone and granite rock formations.
Here i tried the Earthy sand as a pigment -color to extract from and this is the result , but however it was 100% natural and no additives so that the color did not stay long and the color here is sticked less than others.Fabric used here is cotton.
INK-preparation and the pigment¶
Instead of letting the dye bath end with the fabric, I chose to continue listening to the material. The leftover onion skin dye bath still carried color, potential, and information.
Through a simple precipitation process using alum and soda on reused onion extracted color, the liquid slowly transformed. Pigments emerged, settled, and separated—revealing color in its most concentrated form. After drying and grinding, the pigment became a powder: portable, storable, and ready for future use. What was once water and waste became a medium for future marks, drawings, and experiments. This process shifted my understanding of dyeing from a single outcome to an ongoing material cycle.
Steps¶
Using the remaining of onion dye to recycle it and have a piments. by adding to the onion water additives such as alum and sodium carbonate with percentage 1:2 and allow it to dissolve in the water until you can observe it became thicker and there is a separate line created that can be seen in video. After that you can use filter to filter it - coffee filter shall work too.
Pigment on filter as a result too
This process transformed dye waste into reusable pigment and ink, suitable for future textile, art, and design applications.
Referances¶
See you next week .... Yalla !!